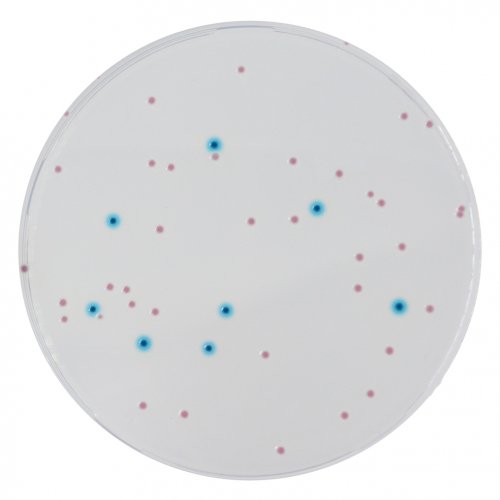

2019/01/16 新品上市--科瑪嘉 "CHROMagar Enterobacteria"
新 品 上 市
科瑪嘉 "CHROMagar Enterobacteria"
-- 科瑪嘉 腸桿菌科 培養基 --
|
CHROMagar Enterobacteria / 科瑪嘉 腸桿菌 培養基
► 產品特色: 1. Easy differentiation between E.coli and other Enterobacteria by the color, unlike with VRBG. 2. Easy reading the intense colored colonies on a clear agar background facilitate the reading, contrary to VRBG, where the small background allows little contrast. |
► 詳細資料請連結:http://www.tpm-tpm.com.tw/product_1.php?prod_id=155













